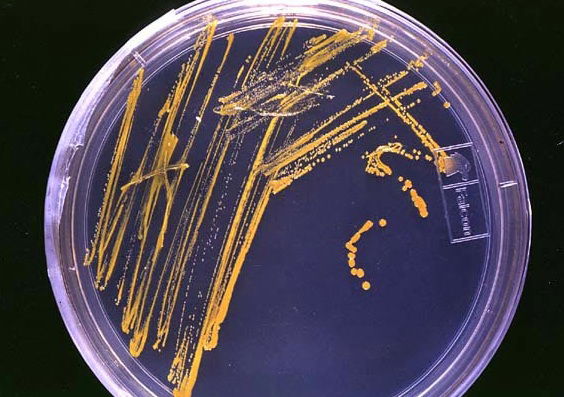
חיידקים

מדענים באיטליה טוענים כי גילו בתוך ענבר (אבן חן) שלושה חרקים בני 230 מיליון שנה, שקפאו לזמן ממושך.
לפי הדיווח בעיתון מעריב, התגלית הזאת עתיקה בכמאה מיליון שנה מהתגלית הקדומה ביותר של חרקים שנלכדו בשרף עצים.
הגילוי הגיע לאחר בדיקה מעמיקה של 70 אלף נטיפים של ענבר שאותרו בצפון מזרח איטליה. בתוכו, נמצאו החיידקים וגם חלק מזבוב עתיק.
דויד גרימלדי, אוצר המוזיאון האמריקאי להיסטוריה של הטבע בניו יורק שחקר את הנושא אמר כי בתגלית הזאת היה ניתן לראות פרטים רבים יותר בהשוואה למקרים דומים בעבר.
בעולם המדעי כבר מכתירים את התגלית הזאת כ"אחת המדהימות" שהתגלו לאחרונה. לטענתם, באמצעות התגלית יהיה ניתן ללמוד על החיים בעבר ועל השינויים שהתחוללו ברבות השנים.
כידוע, עמדת היהדות המסורה לנו היא כי מאז בריאת העולם ועד לימינו חלפו 5,772 שנים בלבד, כך שטענת החוקרים על חיידקים בני מיליוני שנים כמובן שאינה לפי עמדת היהדות.
יש לציין כי לדעת מומחים רבים, אין סתירה בין גילויים מלפני מיליוני שנה לעמדת היהדות. יש המייחסים את הנאמר בבראשית רבה ג' ט': "הקב"ה בונה עולמות ומחריבן", לגילויים היסטוריים שנחשפים מפעם לפעם. אחרים, מצביעים על הנאמר בספר בראשית "והארץ היתה תוהו ובוהו" ומייחסים זאת לתקופה שקדמה לבריאת העולם.






0 תגובות